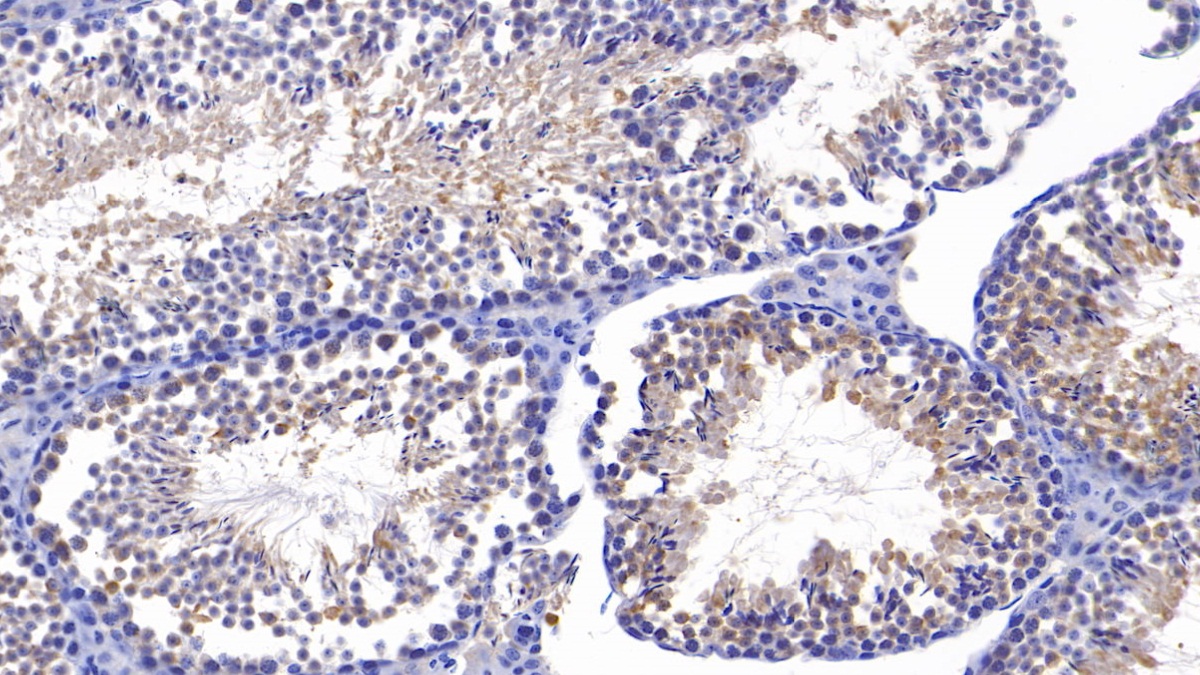

Polyclonal Antibody to Sirtuin 4 (SIRT4)
SIR2L4; Silent Mating Type Information Regulation 2 Homolog 4; SIR2-like protein 4; NAD-dependent protein deacetylase sirtuin-4
- Product No.PAE914Mu01
- Organism SpeciesMus musculus (Mouse) Same name, Different species.
- SourcePolyclonal antibody preparation
- HostRabbit
- Potencyn/a
- Ig Type IgG
- PurificationAntigen-specific affinity chromatography followed by Protein A affinity chromatography
- LabelNone
- Immunogen RPE914Mu01-Recombinant Sirtuin 4 (SIRT4)
- Buffer Formulation0.01M PBS, pH7.4, containing 0.05% Proclin-300, 50% glycerol.
- TraitsLiquid
- Concentration500µg/mL
- Organism Species MoreHomo sapiens (Human), Rattus norvegicus (Rat), Sus scrofa; Porcine (Pig)
- ApplicationsWB,IHC
If the antibody is used in flow cytometry, please check FCM antibodies. - DownloadInstruction Manual
- UOM 20µl100µl 200µl 1ml 10ml
- FOB
US$ 108
US$ 252
US$ 360
US$ 900
US$ 3600
For more details, please contact local distributors!
SPECIFITY
The antibody is a rabbit polyclonal antibody raised against SIRT4. It has been selected for its ability to recognize SIRT4 in immunohistochemical staining and western blotting.
USAGE
Western blotting: 0.5-2µg/mL
Immunohistochemistry: 5-20µg/mL
Immunocytochemistry: 5-20µg/mL
Optimal working dilutions must be determined by end user.
STORAGE
Store at 4°C for frequent use. Stored at -20°C in a manual defrost freezer for two year without detectable loss of activity. Avoid repeated freeze-thaw cycles.
STABILITY
The thermal stability is described by the loss rate. The loss rate was determined by accelerated thermal degradation test, that is, incubate the protein at 37°C for 48h, and no obvious degradation and precipitation were observed. The loss rate is less than 5% within the expiration date under appropriate storage condition.
GIVEAWAYS
INCREMENT SERVICES
-
 Antibody Labeling Customized Service
Antibody Labeling Customized Service
-
 Protein A/G Purification Column
Protein A/G Purification Column
-
 Staining Solution for Cells and Tissue
Staining Solution for Cells and Tissue
-
 Positive Control for Antibody
Positive Control for Antibody
-
 Tissue/Sections Customized Service
Tissue/Sections Customized Service
-
 Phosphorylated Antibody Customized Service
Phosphorylated Antibody Customized Service
-
 Western Blot (WB) Experiment Service
Western Blot (WB) Experiment Service
-
 Immunohistochemistry (IHC) Experiment Service
Immunohistochemistry (IHC) Experiment Service
-
 Immunocytochemistry (ICC) Experiment Service
Immunocytochemistry (ICC) Experiment Service
-
 Flow Cytometry (FCM) Experiment Service
Flow Cytometry (FCM) Experiment Service
-
 Immunoprecipitation (IP) Experiment Service
Immunoprecipitation (IP) Experiment Service
-
 Immunofluorescence (IF) Experiment Service
Immunofluorescence (IF) Experiment Service
-
 Buffer
Buffer
-
 DAB Chromogen Kit
DAB Chromogen Kit
-
 SABC Kit
SABC Kit
-
 Long-arm Biotin Labeling Kit
Long-arm Biotin Labeling Kit
-
 Real Time PCR Experimental Service
Real Time PCR Experimental Service
| Magazine | Citations |
| Growth | Preliminary data on the relationship between circulating levels of Sirtuin 4, anthropometric and metabolic parameters in obese subjects according to growth hormone/insulin-like growth factor-1 status PubMed: 25466907 |
| hindawi | ADHERENCE TO THE MEDITERRANEAN DIET AND CIRCULATING LEVELS OF SIRTUIN 4 IN OBESE 6101254.pdf |
| Oxidative Medicine and Cellular Longevity | Adherence to the Mediterranean Diet and Circulating Levels of Sirtuin 4 in Obese Patients: A Novel Association pubmed:28706576 |
| Elife | SIRT2 deacetylase regulates the activity of GSK3 isoforms independent of inhibitory phosphorylation Pubmed:29504933 |
| Catalog No. | Related products for research use of Mus musculus (Mouse) Organism species | Applications (RESEARCH USE ONLY!) |
| RPE914Mu01 | Recombinant Sirtuin 4 (SIRT4) | Positive Control; Immunogen; SDS-PAGE; WB. |
| PAE914Mu01 | Polyclonal Antibody to Sirtuin 4 (SIRT4) | WB,IHC |
| LAE914Mu71 | Biotin-Linked Polyclonal Antibody to Sirtuin 4 (SIRT4) | WB |
| KSE914Mu01 | ELISA Kit DIY Materials for Sirtuin 4 (SIRT4) | Main materials for "Do It(ELISA Kit) Yourself" |